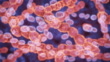

Bacteria Lactococcus - Vídeo de stock 4K
Lactococcus bacteria,Good microorganisms concept

COMPRAR UMA LICENÇA
Todas as licenças royalty-free incluem direitos globais de utilização, proteção abrangente e preços simples com possibilidade de descontos de volume
475,00 €
EUR
DETALHES
Crédito:
Creative nº:
1405455928
Tipo de licença:
Coleção:
Creatas Video
Tamanho máx.:
3840 x 2160 px - 1 GB
Duração do clip:
00:00:14:00
Data do upload:
Local:
Thailand
Inf. sobre autorização:
Não é necessária uma autorização
Masterizado para:
QuickTime 10-bit ProRes 422 (HQ) 4K 3840x2160 30p
Categorias:
- Microscópio,
- Fermentar,
- Intestino,
- Laboratório,
- Bactéria,
- Célula,
- Doença,
- Meningite,
- Abdómen,
- Anaeróbio - Processo de organismo vivo,
- Antibiótico,
- Aula de Biologia,
- Bactéria Bacillus subtilis,
- Bactéria Gram-Positiva,
- Biologia,
- Biotecnologia,
- Bronquite,
- Ciência,
- Comida,
- Constipação e Gripe,
- Contaminação,
- Coágulo,
- Cuidados de Saúde e Medicina,
- Código Binário,
- Cólon,
- Divisão,
- Emoção positiva,
- Endocardite,
- Filme - Imagem em Movimento,
- Formato de Alta Definição,
- Futurista,
- Horizontal,
- Indústria,
- Investigação Médica,
- Iogurte,
- Leite,
- Local de Filmagem Não Americano,
- Medicação,
- Microbiologia,
- Microbioma humano,
- Microrganismo,
- Patogénico,
- Pneumonia,
- Probiótico,
- Procariota,
- Queijo,
- Realidade virtual,
- Resolução 4K,
- Sem Higiene,
- Separar,
- Soro de Leite Coalhado - Laticínio,
- Streptococcus,
- Tailândia,
- Tempo real,
- Ácido,